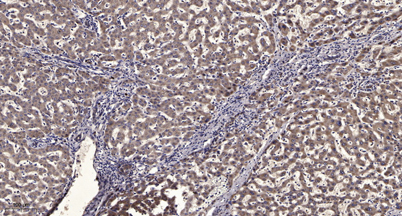

SMYD2 rabbit pAb
 One-click to copy product information
One-click to copy product information$148.00/50µL $248.00/100µL
| 50 µL | $148.00 |
| 100 µL | $248.00 |
Overview
| Product name: | SMYD2 rabbit pAb |
| Reactivity: | Human;Mouse;Rat |
| Alternative Names: | SMYD2; KMT3C; N-lysine methyltransferase SMYD2; HSKM-B; Histone methyltransferase SMYD2; Lysine N-methyltransferase 3C; SET and MYND domain-containing protein 2 |
| Source: | Rabbit |
| Dilutions: | WB 1:500-2000;IHC-p 1:50-300; ELISA 2000-20000 |
| Immunogen: | The antiserum was produced against synthesized peptide derived from human SMYD2. AA range:99-148 |
| Storage: | -20°C/1 year |
| Clonality: | Polyclonal |
| Isotype: | IgG |
| Concentration: | 1 mg/ml |
| Observed Band: | 50kD |
| GeneID: | 56950 |
| Human Swiss-Prot No: | Q9NRG4 |
| Cellular localization: | Cytoplasm, cytosol . Nucleus . |
| Background: | SET and MYND domain containing 2(SMYD2) Homo sapiens SET domain-containing proteins, such as SMYD2, catalyze lysine methylation (Brown et al., 2006 [PubMed 16805913]).[supplied by OMIM, Nov 2008], |
-
 Western Blot analysis of various cells using SMYD2 Polyclonal Antibody diluted at 1:2000
Western Blot analysis of various cells using SMYD2 Polyclonal Antibody diluted at 1:2000 -
 Western blot analysis of lysate from HT29 cells, using SMYD2 antibody.
Western blot analysis of lysate from HT29 cells, using SMYD2 antibody. -
Immunohistochemical analysis of paraffin-embedded human liver cancer. 1, Antibody was diluted at 1:200(4° overnight). 2, Tris-EDTA,pH9.0 was used for antigen retrieval. 3,Secondary antibody was diluted at 1:200(room temperature, 45min).
Immunohistochemical analysis of paraffin-embedded human liver cancer. 1, Antibody was diluted at 1:200(4° overnight). 2, Tris-EDTA,pH9.0 was used for antigen retrieval. 3,Secondary antibody was diluted at 1:200(room temperature, 45min).

 Manual
Manual